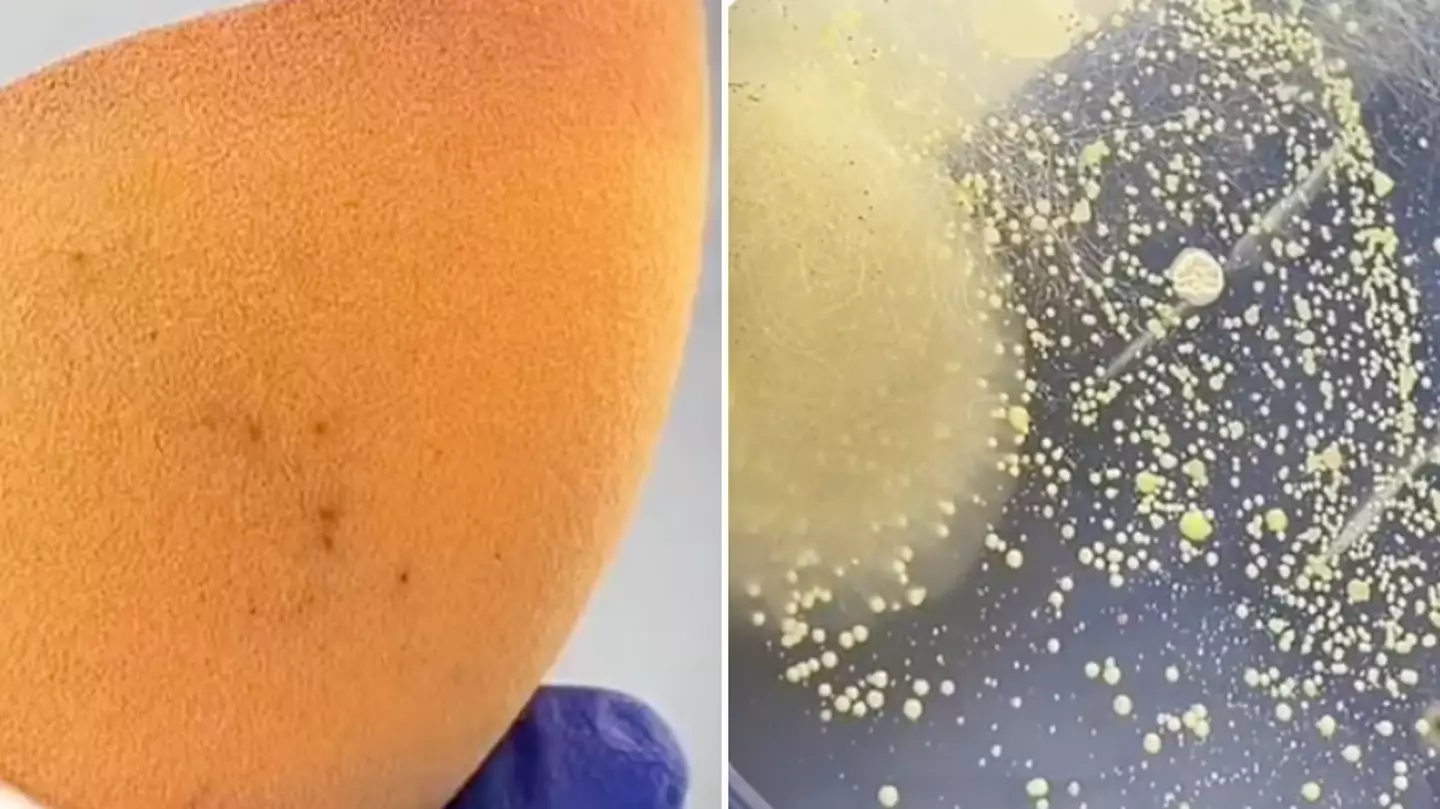

Make-Up
Our make-up articles include the latest product releases, celebrity make-up trends, skincare tips and more. Find out what's new in the world of beauty and how to get the look you want.
Our make-up articles include the latest product releases, celebrity make-up trends, skincare tips and more. Find out what's new in the world of beauty and how to get the look you want.
Our make-up articles include the latest product releases, celebrity make-up trends, skincare tips and more. Find out what's new in the world of beauty and how to get the look you want.


.png)
.png)

.png)

.png)